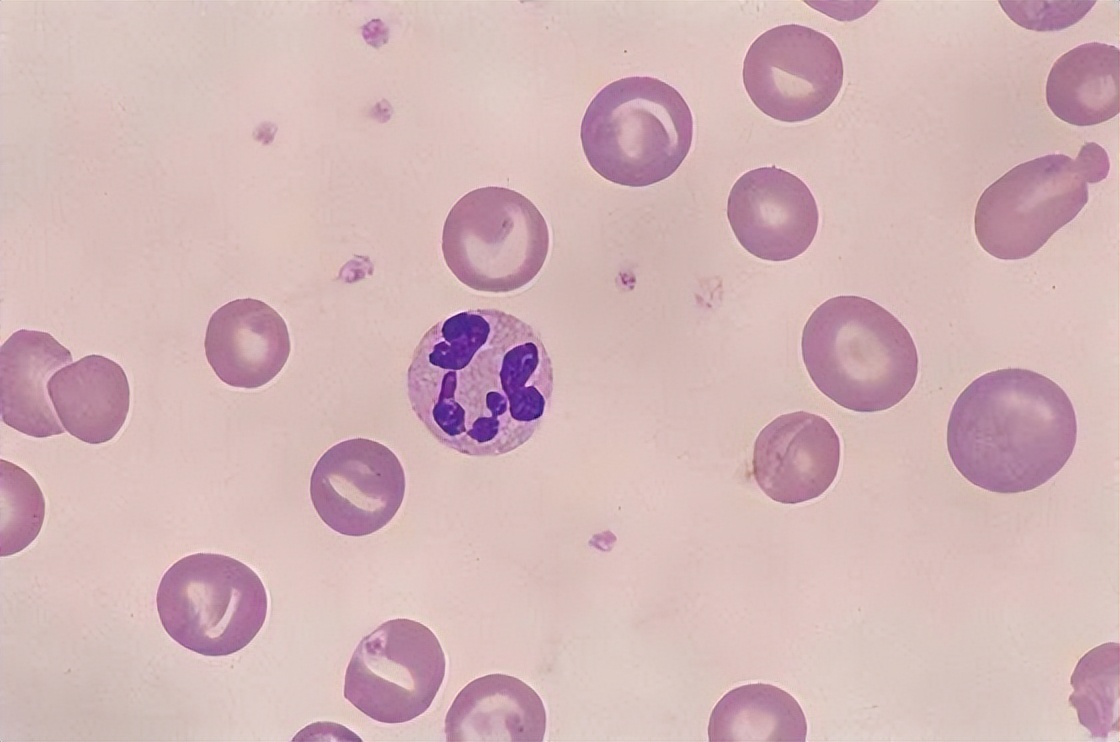
血常规四个指标升高需要注意什么,血常规检查之后才看哪三项

血常规检查是一种非常基础常规的检查,可以通过检查红细胞白细胞以及血红蛋白的情况来判断身体存在的潜在风险。
01
血常规检查正常能排除哪些疾病?
如果血常规检查正常,则说明患者目前没有感染,也没有出现贫血以及血液系统疾病。
血常规检查仅仅代表目前的状况,部分患者熬夜后再进行血常规检查,可能出现的结果是不一样的,所以做血常规检查也要保证情绪稳定,前一天晚上不要熬夜。
张国雄医生认为即使血常规检查正常,代表性也较短暂。

血常规主要检查项目是白细胞系列:白细胞介素、中细淋巴比例、淋巴细胞
这几个指标能够反映炎症的情况,不同类型的炎症,其反应的指标也是不同的:
中性粒细胞异常提示细菌感染;
淋巴细胞、单核细胞异常提示疟疾和结核;
嗜酸性粒细胞异常提示寄生虫感染。
另外需要注意白细胞升高幅度剧烈,甚至出现不成熟细胞需要警惕白血病的出现。

02
血常规检查中,如果这3个指标升高,建议再做进一步检查
1、淋巴细胞数量升高
淋巴细胞占据人体血液中成分的近36%,,是依靠内源性分泌和外源性补充来进行分合。
淋巴细胞的异常可分为两种类型,一种是生理性的,一种是病理性的。
如果因为某些因素导致体内有炎症,那么淋巴细胞的数量就会比正常情况下有所增高,这种情况就需要服用消炎药来缓解。
淋巴细胞的数量也不能太少,太少的话要警惕白血病以及其他疾病,需要做进一步检查。
2、中性粒细胞增多
做血常规检查的过程当中,有一个项目叫中性粒细胞,这在血常规检查当中是一个占比比较大的细胞,可以通过中性粒细胞的数量来判断是否存在疾病。
当淋巴细胞当中,中性粒细胞超过了参考上限时,属于中粒细胞增多中粒细胞增多又分为生理性增多和病理性增多。
生理性的变化可能是运动量过大或检查之前温度较低所引起的,如果是病理性的就要引起高度疾病,这大多是疾病产生的一种警告,常常与急性感染有关,需要及时消炎治疗。
3、血小板
血小板存在于血液当中,主要功能是止血,如果身体内有伤口学就会通过血小板的凝血功能迅速凝结,并不会因此而大量失血。
血小板异常包括分布宽度、压积、平均体积和数目的异常, 如果发现血小板数量减少,容易出现体内出血,治疗不及时会诱发休克或昏迷。
如果发现血小板数量增多,容易诱发血栓和动脉血管粥样硬化。
如果血小板数值比上限高或者比下限低,都是血小板异常,需要进一步做检查判断是否有血液疾病。

03
血常规检查可以查出癌症吗?
血常规检查是不能查出癌症的,当然有一些人也可能会出现血液异常的情况,这个时候可以进一步做检查。
因为在血常规检查当中,只有少部分的癌症患者会出现明显的异常,大部分的癌症患者在血常规检查的时候并不会发现身体有什么毛病,即便一些癌症患者检查出的血常规,也跟我们正常人一样。
患有白血病的人在血常规检查当中一般会发现有变异,而癌症属于一种慢性的损耗性疾病,对于癌症患者来说,检查结果往往不会出现太大的异常,所以大家在平时要结合其他多项检查来综合判断。

04
做血常规检查前需要注意什么?
虽然血常规检查是一种常规检查,但是也要做好检查前的注意事项,否则会影响检查结果:
1、做血常规检查之前一定要注意饮食清淡,不要吃太油腻高蛋白的食物,避免大量饮酒酒精成分,都会影响检验结果;
2、接受血常规检查前8个小时最好不吃东西,如果吃东西的话可能会影响到检查指标,最好在检查前一天的晚8个小时之后禁食,水也不要喝。
3、有些人在进行血常规检查的时候会感觉非常紧张,这种紧张的情绪是不利于检查结果的,所以大家一定要注意保持好自己稳定的情绪,避免因为恐惧造成血管的收缩,增加采血的困难。

虽然我们经常做血常规检查,但每一次检查的原因都是不一样的,检查结果也不一样,当医生要求我们做血常规检查时,大家就要按照要求去做,这样才能及时发现身体当中存在的问题及早做治疗!